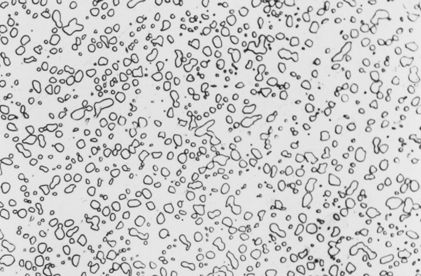

前言:随着钢的成分不同以及处理工艺不同,钢中将出现:渗碳体、珠光体、魏式氏织、铁素体、贝氏体(其中又分为上贝氏体、下贝氏体、和粒状贝氏体)、奥氏体、马氏体、回火马氏体、回火托氏体、回火索氏体。现简单介绍一下这些组织的基本形态,以便在实践中加以区别。
渗碳体是铁和碳的化合物,Fe3C,其含碳量为6.69%,在合金中形成(Fe,M)3C,渗碳体硬而脆,硬度为800HB。在钢中常呈网络状、半网状、片状、针片状和粒状分布。

网状渗碳体200×

针状渗碳体(魏氏组织)200×

粒状渗碳体500×

T12 退火态500×

珠光体是铁素体和渗碳体的机械混合物,它是钢的共析转变产物,其形态是铁素体和渗碳体彼此相间形如指纹,呈层状排列。按碳化物分布形态又可分为片状珠光体和球状珠光体二种。片状珠光体又可分为粗片状、中片状和细片状三种。

片状珠光体200 ×

T8 退火态500×



球状珠光体,经球化退火获得,渗碳体成球粒状分布在铁素体基体上;渗碳体球粒大小,取决于球化退火工艺,特别是冷却速度。球状珠光体可分为粗球状、球状和细球状和点状四种珠光体。
球状珠光体500x

球状珠光体1000x

亚共析钢加热时因过热而形成粗晶,冷却时又快,故铁素体除沿奥氏体晶界成网状析出外,还有一部分铁素体从晶界向晶内按切变机制形成并排成针状独自析出,这种分布形态的组织称为魏氏组织。
过热过共析钢冷却时渗碳体也会形成针状自晶界向晶内延伸而形成魏氏组织。

粗晶魏氏组织200×

粗晶魏氏组织铁素体200×

是钢的奥氏体在珠光体转变区以下,Ms点以上的中温区转变的产物。它也是铁素体与渗碳体两相组织的机械混合物,但形态多变,不象珠光体那样呈层状排列。
从形状特征来看,可将贝氏体分为羽毛状、针状和粒状三类。
上贝氏体
上贝氏体特征是:条状铁素体大体平行排列,其间分布有与铁素体针轴平行的细条状(或细短杆状)渗碳体,呈羽毛状。

羽毛状贝氏体500×

羽毛状贝氏体500×
下贝氏体
下贝氏体呈细针片状,有一定取向,较淬火马氏体易受侵蚀,极似回火马氏体,在光镜下极难区别,在电镜下极易区分;在针状铁素体内沉淀有碳化物,且其排列取向与铁素体片的长轴成55~60度,下贝氏体内不含孪晶,有较多的位错。

下贝氏体、马氏体、残奥及少量羽毛状上贝氏体 200×

下贝氏体、马氏体、残余奥氏体200×
粒状贝氏体
外形相当于多边形的铁素体,内有许多不规则小岛状的组织。
当钢的奥氏体冷至稍高于上贝氏体形成温度时,析出铁素体有一部分碳原子从铁素体并通过铁素体/奥氏体相界迁移到奥氏体内,使奥氏体不均匀富碳,从而使奥氏体向铁素体的转变被抑制。这些奥氏体区域一般型如孤岛,呈粒状或长条状,分布在铁素体基体上,在连续冷却过程中,根据奥氏体的成分及冷却条件,粒贝内的奥氏体可以发生如下几种变化。


粒状贝氏体200×

空冷贝氏体钢500×

空冷贝氏体钢200×

粒状贝氏体10000×
粒状贝氏体,铁素体基体上布有颗粒状碳化物(小岛组织原为富碳奥氏体,冷却时分解为铁素体及碳化物,或转变为马氏体或仍为富碳奥氏体颗粒)。

羽毛状贝氏体8000x
羽毛状贝氏体,基体为铁素体,条状碳化物于铁素体片边缘析出。
下贝氏体
下贝氏体,针状铁素体上分布有小片状碳化物,片状碳化物与铁素体的长轴大致是55~60度角。

下贝氏体8000x
☞来源:热处理技术研究中心
(本平台"常州精密钢管博客网"的部分图文来自网络转载,转载目的在于传递更多技术信息。我们尊重原创,版权归原作者所有,若未能找到作者和出处望请谅解,敬请联系主编微信号:steel_tube,进行删除或付稿费,多谢!)

